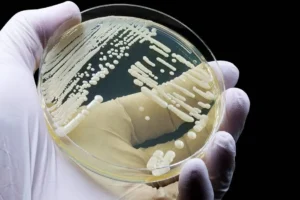

Redacción: Carolina Herrera Con el proyecto Northern Lights, Noruega inaugura un sistema pionero que captura, transporta y almacena dióxido de carbono a más...
Archivo13 octubre, 2025
Redacción: Naomi Vargas El cambio climático ya no es un pronóstico: es una realidad una deuda que México vive a diario El cambio climático ya no es un...
Redacción: Daniela Paredes Rocha El calentamiento global no solo daña al planeta: también da origen a nuevos patagones. Candidozyma auris un hongo resistente...
Columna Daniel Lee Crear sindicatos con enfoque de género no es un gesto simbólico; es una obligación democrática y una reparación pendiente. En...
Redacción: Hena M. Andrés Cuevas Un informe reciente de DNV revela que, aunque las políticas energéticas de Estados Unidos han ralentizado su transición...